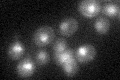
YLR103C
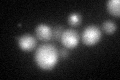
YLR103C
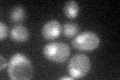
YLR103C

View description
DNA replication initiation factor; recruited to MCM pre-RC complexes at replication origins; promotes release of MCM from Mcm10p, recruits elongation machinery; mutants in human homolog may cause velocardiofacial and DiGeorge syndromes
Localization:
Intensity:
Fold change:
Significance:
-
C’ GFP library in SD
nucleus23.42 -
N' NOP1pr-GFP in SD

nucleus35.3359 -
N' TEF2pr-mCherry in SD

nucleus11.7829 -
N' NATIVEpr-GFP in SD

nucleus22.7676 -
N' TEF2pr-VC and Cyto-VN in SD

#N/A0 -
C’ GFP library in SD+DTT
nucleus23.270.99No -
C’ GFP library in SD+H2O2
nucleus26.31.12No -
C’ GFP library in Starvation Media

nucleus18.590.79Yes -
C’ GFP library on the background of Pup2-DaMP

nucleus -
C’ GFP library on the background of CCT mutant

nucleus21.25070.90711No
